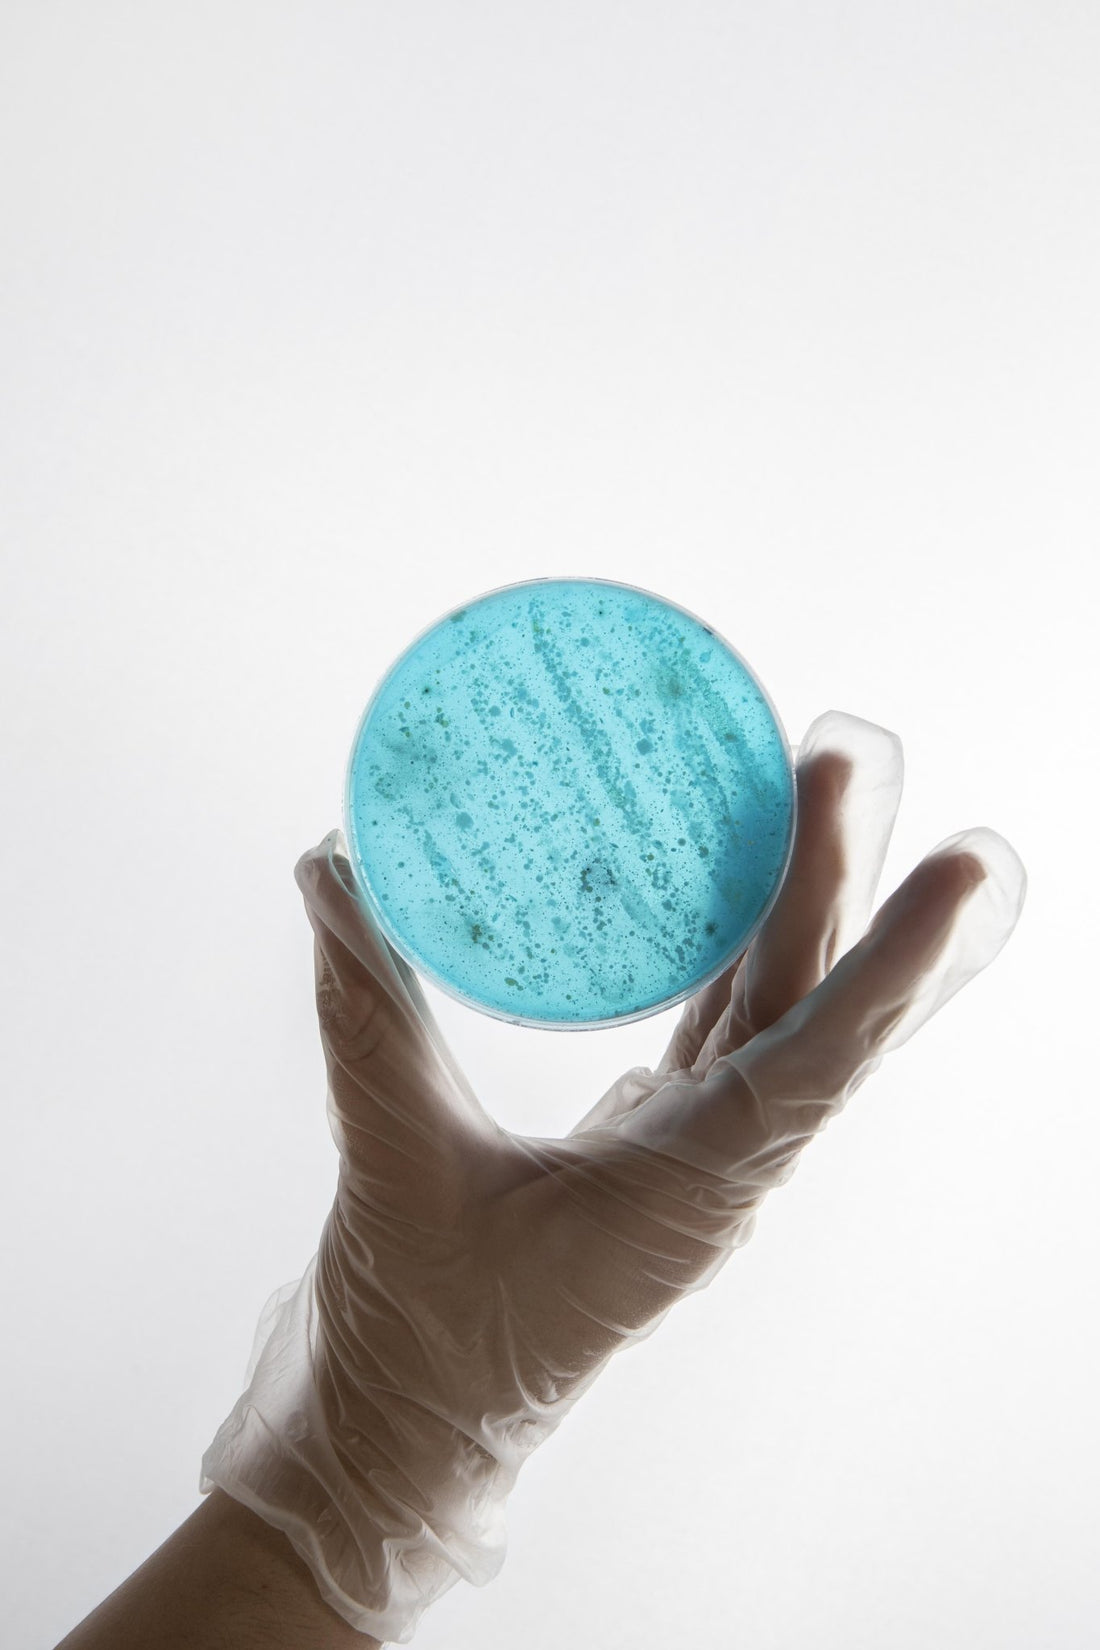

Research

The results of Daigo's research by Hiromi Shinya
DAIGO – an effective fight against the Helicobacter Pylori microbe! Hiromi Shinya MD, Professor of the Department of Medical Sciences university named after Einstein's. A world-recognized Japanese surgeon who contributed...
The results of Daigo's research by Hiromi Shinya
DAIGO – an effective fight against the Helicobacter Pylori microbe! Hiromi Shinya MD, Professor of the Department of Medical Sciences university named after Einstein's. A world-recognized Japanese surgeon who contributed...

Does Daigo Lux affect telomere length?
Life Lenght, the leading European biotechnology laboratory, conducted the study for Daigo LUX product with the following results: Is it possible to prolong an active and happy life in a...
Does Daigo Lux affect telomere length?
Life Lenght, the leading European biotechnology laboratory, conducted the study for Daigo LUX product with the following results: Is it possible to prolong an active and happy life in a...

Daigo and Gut Microbiota - Tokyo Medical and De...
Intestinal Microflora Research Report It was confirmed that the extract fermented with lactic acid bacteria (LEX from the English Lactobacillus Fermentation Extract, trade mark "Daigo") significantly reduces the level of...
Daigo and Gut Microbiota - Tokyo Medical and De...
Intestinal Microflora Research Report It was confirmed that the extract fermented with lactic acid bacteria (LEX from the English Lactobacillus Fermentation Extract, trade mark "Daigo") significantly reduces the level of...

The effect of lactobacillus fermentation extract
THIS ARTICLE IS PUBLISHED IN THE FOLLOWING JOURNAL "DAV PRESS": NUTRITION AND BIOLOGICALLY ACTIVE FOOD ADDITIVES Effect exerted by Lactobacillus fermentation extract (LEX from the English Lactic Acid Bacteria-Fermented Soy...
The effect of lactobacillus fermentation extract
THIS ARTICLE IS PUBLISHED IN THE FOLLOWING JOURNAL "DAV PRESS": NUTRITION AND BIOLOGICALLY ACTIVE FOOD ADDITIVES Effect exerted by Lactobacillus fermentation extract (LEX from the English Lactic Acid Bacteria-Fermented Soy...
Tamotsu study: changes in the phospholipid comp...
Changes in the phospholipid composition of erythrocyte membranes in Alzheimer's disease Original scientific article Dement Geriatr Cogn Disord Extra 2012;2:298-303 DOI: 10.1159/000341603 Published online: August 15, 2012 \u00a9 2012 S....
Tamotsu study: changes in the phospholipid comp...
Changes in the phospholipid composition of erythrocyte membranes in Alzheimer's disease Original scientific article Dement Geriatr Cogn Disord Extra 2012;2:298-303 DOI: 10.1159/000341603 Published online: August 15, 2012 \u00a9 2012 S....

Tamotsu studies: Taking plasmalogen with food i...
Intake of plasmalogen with food increases the content of plasmalogen in the membranes of erythrocytes in rats Mawatari et al. Lipids in Health and Disease 2012,11:161 http://www.lipidworid.com/content/11/1/161 https://pubmed.ncbi.nlm.nih.gov/23170810/ Shiro Mawatari1*,...
Tamotsu studies: Taking plasmalogen with food i...
Intake of plasmalogen with food increases the content of plasmalogen in the membranes of erythrocytes in rats Mawatari et al. Lipids in Health and Disease 2012,11:161 http://www.lipidworid.com/content/11/1/161 https://pubmed.ncbi.nlm.nih.gov/23170810/ Shiro Mawatari1*,...